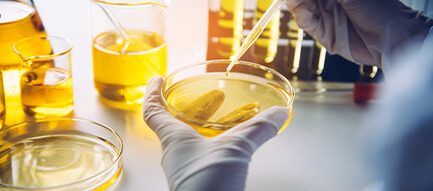

Kullanılmış Yağ Analizleri: Doğru Numune Almanın Püf Noktaları
Yol veya yol dışı araçlarda ya da sabit endüstriyel ekipmanlarda ağır iş yapın veya yapmayın, bu uzmanlaşmış bir laboratuvar tarafından rutin olarak kullanılmış yağ analizi yapılması demektir. Kirleticiler ve genel stabilite için ekipmanınızın içerisinde alan yağın kontrol edilmesi, uygun değişim aralıklarını belirlemenize yardımcı olurken aşınma nedenlerini ortaya çıkararak ekipmanınızın korunmasına da yardım eder. Örneğin; eğer analiz, çok yüksek kir, demir, alüminyum veya krom seviyesi ortaya koyarsa hava sızıntınız olabilir ya da belki de yeni bir filtreye veya hava borusuna ihtiyacınız var. Kullanılmış yağ analizi, size ekipmanınızı korumak için ele almanız gereken konuların bir bildirimini sunacaktır. Yağ numunelerinin toplanması, çok kolay değildir ve şirketlerin iyi numunelendirme uygulamalarının önemini fark etmesi gerekmektedir. Laboratuvar, cismen 10 mikrondan az partiküllere bakacaktır.
Eğer havadaki veya dış kaynaktan partiküller almanızın ardından numunenizin içine girerse ki bu çok kolay olabilir, sonuçlarınız değişecektir. Birkaç basit adımı izlemek, sisteminizdeki yağı temsil eden iyi ve temiz bir numune almanızı sağlayabilir.
Sürekli olarak aynı noktadan numune alın. Ekipman çalışırken ve yağ çalışma sıcaklığında sistem içerisindeki aktif bir akıntıdan numune almak en iyisidir. Ancak en önemlisi; sürekli olarak aynı yerden numune almaktır. Aksi takdirce, bir analizden bir sonrakine çok fazla değişiklik gösteren sonuçlar elde edebilirsiniz.
Düzenli aralıklarla numuneleri alın. Eğer numuneler arasında çok uzun beklerseniz - mesela 1.000 saate karşılık 100 - anormal gözüken aşınma izleri göreceğiniz kesin. Yeteri kadar sıklıkla ve düzenli olarak numune alın böylece laboratuvar, sisteminizdeki değişikliğini izleyebilecek güzel bir referans hattı oluşturabilir.
Asla boşaltma tavasından numune almayın. Bu noktanın numune alınacak en kolay yer olduğu düşünülse de, önceki değişimlerden boşaltma tavasının kirleticiler ve atıklarla dolu olması analizlerin sizi yanlış yönlendirmesine sebep olacaktır.
Temiz, kuru bir şişe kullanın. Numuneyi almaya hazır olana kadar şişeyi açmayın. Temiz olduğundan emin olun ve numuneyi alır almaz hızlıca kapatın. Muhtemelen yüzlerce veya hatta binlerce galon yağ saklayan bir rezervuarı temsilen yaklaşık 4 oz alacaksınız. Laboratuvar, yapacağı çok sayıda testin her biri için bundan sadece küçük bir miktar kullanacaktır.
Şişeyi tamamen doldurmayın. Şişede küçük bir boşluk bırakın böylece laboratuvar teknisyeni, dipte toplanan partikülleri dağıtmak için şişeyi çalkalayabilir.
Numuneyi doğru bir şekilde ve dikkatlice etiketleyin. Marka ve ürün adına ek olarak tam yağ viskozitesini veya SAE sınıfını tanımladığınızdan emin olun. Birim üzerinde ekipman türünü, çalışma saatini ayrıca bunların yanı sıra son yağ değişikliğini takiben geçen saati gösterin. Ekipmanı her defasında tam olarak aynı terminoloji ile tanımlayın - aksi halde bilgisayar bunun başka bir ekipman parçası olduğunu düşünecek ve yeni bir veri tabanı başlatacaktır. Laboratuvara ne kadar doğru bilgi verirseniz size o kadar kesin analizler sunabilirler.
Bir kişi görevlendirin. İdeal olanı, tutarlılığı sağlamak amacıyla numune almayı bilen bir kişi olacaktır.




